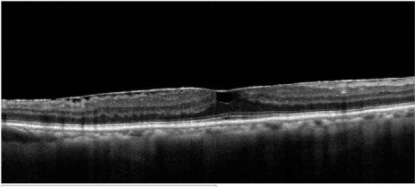
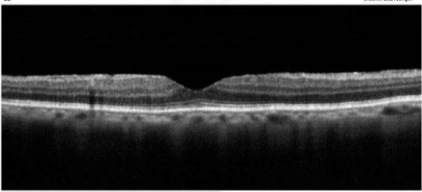

黃斑部皺摺(Macular Pucker):什麼!眼睛也會長皺紋?!
什麼是黃斑部皺褶?
就是黃斑部表層上有不正常增生的纖維膜(又稱為視網膜上膜或前膜),纖維膜本身收縮造成底下視網膜扭曲變形,進而影響了我們的中心視力。


為什麼會有黃斑部皺褶?
年輕時的玻璃體是透明均勻的膠狀,且跟視網膜緊密相連的。但隨者年齡的增加,膠原蛋白纖維會被分解,造成玻璃體液化而萎縮。萎縮的過程中原本緊黏的玻璃體與視網膜也會分離,稱為玻璃體後剝離(飛蚊症的產生)。
原發性的黃斑部皺褶(病程較慢)一般認為是自然退化過程中玻璃體後剝離時,殘留了一小部分的玻璃體或是牽扯的力量造成視網膜最內層(內限膜)出現裂縫,使得視網膜內的色素上皮細胞跟神經膠細胞跑出來,而在視網膜表面增生形成疤痕。
續發性的黃斑部皺褶(病程較快)原因很多,例如葡萄膜炎,外傷,視網膜血管阻塞,視網膜裂孔或剝離,老年性黃斑部退化,眼內手術等。都有可能因為局部發炎反應造成玻璃體視網膜介面異常,而產生增生的纖維膜。
黃斑部皺褶會有什麼症狀?
- 中心視物慢慢模糊、扭曲變形
- 閱讀的時候調焦有困難,包括利用各種輔助工具時症狀仍持續
- 在中心視野看到灰色不明物體,無法去除
- 更嚴重者,中心視物呈黑色區塊,無法去除

因為纖維膜增生過程緩慢早期大多無症狀。但是隨著纖維膜變大變厚,開始出現視力模糊的症狀。接著因為纖維膜收縮連帶影響視網膜血管,造成黃斑部水腫進而視覺扭曲變形大幅影響視力。
黃斑部皺褶該如何診斷?
主要藉由眼科醫師在散瞳後,利用 ①眼底鏡直接檢查黃斑部是否有異狀。近年來檢查儀器的進步 ②光學同調斷層儀(OCT),利用先進的光學技術快速掃描後,可以取得清晰的玻璃體視網膜介面及視網膜黃斑部影像。 ③螢光眼底圖FAG也幫助醫生更早一步檢查出肉眼不易察覺的早期病變。
圖1:黃斑部皺摺螢光眼底圖FAG

圖2:黃斑部皺摺光學同調斷層儀圖OCT

黃斑部皺褶什麼時候該手術治療?
該如何治療:因為纖維膜增生過程緩慢,因此疾病初期先以觀察為主。國外文獻指出,有將近80%的患者在眼科追蹤的兩到四年內,視力沒有出現明顯的下降。甚至有極少部分的患者,纖維膜會自然脫落吸收,不藥而癒。部分患者的纖維膜位置離黃斑部中央較遠因此仍維持不錯視力。但若是纖維膜逐漸增生增厚收縮造成視力明顯下降或是視物扭曲等症狀影響生活 (一般指標視力:快速降低或低於0.5),就建議開刀治療。

開刀治療的方式為23G/25G微創玻璃體切除手術(健保給付) 病人在術後並不要趴。局部麻醉手術時間約三十分鐘。先將玻璃體清除後,再一併移除增生的視網膜上膜。術後視力先些微下降而後一般需要約六個月的時間讓視網膜受損的神經纖維和感光細胞回復(無法百分之百復原),但根據統計50%~75%患者視力會有進步。至於手術後的復發率,原發性少于5%,但續發性大約在10-20%之間。

嚴重早期手術併發症:眼內炎(0.4%)、眼內出血(0.4%)、視網膜剝離(4%)
最常見的後期手術合併症:術後六個月左右造成白內障增加。部份患者需手術。
本院備有全套糖尿病視網膜病變檢查及治療設備
包括:
- 裂隙燈及前置鏡
- 直接、間接眼底鏡
- 彩色眼底攝影儀
- 螢光血管攝影儀
- 眼科B型超音波儀
- 自體螢光眼底攝影儀
- 眼部無輻射電腦斷層掃描儀(OCT)
- 視網膜雷射儀
- 視網膜冷凍儀
- 玻璃體吸切儀
【注意】
*檢查含散瞳約需一小時;散瞳後會畏光、視力模糊約8小時,當天請攜帶太陽眼鏡(墨鏡)且最好有親友陪同,自己不要騎車或開車前來就診
上明眼科:治療黃斑部疾病的專家
諮詢專線:楠梓 (07) 362-1131 轉 9 / 仁武 (07) 371-1470 轉 9





